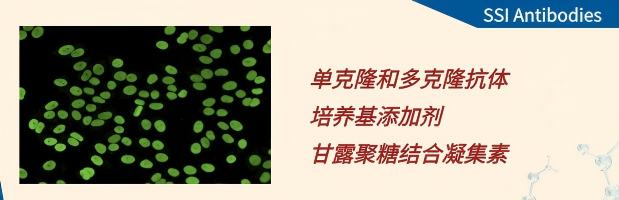
产品细节图片2

相关产品推荐更多 >
万千商家帮你免费找货
0 人在求购买到急需产品
- 详细信息
- 文献和实验
- 技术资料
- 库存:
咨询
- 供应商:
维百奥生物

维百奥生物可提供SSI Antibodies品牌产品。
- 【声明1】我司本网页所展示产品列表、Logo、图片、商标、品牌中英文名字,仅作为客观展示产品所用,如有侵权,请联系随时联系我司。
- 【声明2】我司不销售归类为危险品或其他违规品的产品,但由于本行业产品货号、型号众多,我司在发布时,难免遗漏,如在网页上显示某一货号或品名属于危险品或其他违规品,不代表我司倾向宣传或有意愿销售该产品;欢迎各界朋友批评指正,我们将立即改正。
- 【声明3】本网页所展示的品牌和产品,仅用于科学研究,不可用于人体、不可用于诊断或治疗。
SSI Antibodies开发、生产和销售单克隆与多克隆抗体,以及培养基添加剂和MBL标准品。其抗体具有以下优势:丹麦原研生产;严格的克隆筛选标准确保抗体高性能表现;拥有多年针对多种毒素抗原开发高效价单/多克隆抗体的丰富经验;全球科学家持续验证抗体实验结果,并不断完善抗体性能数据库。SSIAntibodies公司产品包括单克隆和多克隆抗体、培养基添加剂、甘露聚糖结合凝集素。
▍SSI Antibodies抗体类别
| Herbicide & Pesticide Antibodies | Coagulation Antibodies | Serum & Plasma Protein Antibodies | Ricin Antibodies |
| Enzyme & Kinase Substrate Antibodies | Complement Antibodies | Infectious Disease Antibodies | Allergy Antibodies |
| Bordetella Pertussis Antibodies | Nuclear Antibodies | Metabolic Marker Antibodies | Tetanus Toxin Antibodies |
| Botulinum Toxin Antibodies | Biomarker Antibodies | Diphtheria Toxin Antibodies | Viral Antibodies |
▍SSI Antibodies部分产品列表
| Product name | Art. No. | Packing |
| HYB 314-01 Anti Gliadin peptid | 100964; 100965 | 0.2 mL; 1.0 mL |
| HYB 314-02 Anti Gliadin peptid | 100966; 100967 | 0.2 ml; 1.0 ml |
| HYB 099-01 Anti Ovalbumin (chicken) | 100849; 100850 | 0.2 mL; 1.0 mL. |
| HYB 099-02 Anti Ovalbumin (chicken | 100851; 100852 | 0.2 mL; 1.0 mL |
| HYB 099-09 Anti Ovalbumin (chicken) | 100853; 100854 | 0.2 mL; 1.0 mL |
| HYB 099-11 Anti Ovalbumin (chicken) | 100855; 100856 | 0.2 mL; 1.0 mL |
| HYB 094-05 Anti Ovalbumin (chicken, denatured) | 100839; 100840 | 0.2 mL; 1.0 mL |
| HYB 094-06 Anti Ovalbumin (chicken, denatured) | 100841; 100842 | 0.2 mL; 1.0 mL |
| HYB 094-07 Anti Ovalbumin (chicken, denatured) | 100843; 100844 | 0.2 mL; 1.0 mL |
| HYB 111-05 Anti Acetylcholinesterase (human brain, AChE) | 100864; 101113 | 0.2 mL; 1.0 mL |
| HYB 097-04 Anti Alpha-fetoprotein (human, AFP) | 100845; 100846 | 0.2 mL; 1.0 mL |
| HYB 097-09 Anti Alpha-fetoprotein (human, AFP) | 100847; 100848 | 0.2 mL; 1.0 mL |
| HYB 310-04 Anti Amyloid β-peptide | 100960; 100961 | 0.2 mL; 1.0 mL |
| HYB 310-08 Anti Amyloid β-peptide | 100962; 100963 | 0.2 mL; 1.0 mL |
| HAH 002-01 Anti Human Butyrylcholinesterase | 96970; 101075 | 0.2 mL; 1.0 mL |
| HAH 002-01B Anti Human Butyrylcholinesterase, biotinylated | 97873 | 0.1 mL |
| HYB 332-01 Anti desLys β2-microglobulin | 55505; 101077 | 0.2 mL; 1.0 mL |
| HYB 057-02 Anti Estradiol-17β | 100826; 100827 | 0.2 mL; 1.0 mL |
| HYB 314-01 Anti Gliadin peptid | 100964; 100965 | 0.2 mL; 1.0 mL |
| HYB 314-02 Anti Gliadin peptid | 100966; 100967 | 0.2 mL; 1.0 mL |
| HYB 131-01 Anti MBL (human) | 100882; 100883 | 0.2 mL; 1.0 mL |
| HYB 131-10 Anti MBL (human) | 100884; 100885 | 0.2 mL; 1.0 mL |
| HYB 131-01B Anti MBL (human), biotinylated | 102337 | 0.1 mL |
| HYB 131-11 Anti MBL (human) | 100886; 100887 | 0.2 mL; 1.0 mL |
| HYB 131-14 Anti MBL (human, horse, pig) | 100888; 100889 | 0.2 mL; 1.0 mL |
| HYB 131-18 Anti MBL (rat, human) | 100890; 100891 | 0.2 mL; 1.0 mL |
| SSI-HYB 364-02 Anti Mouse Major Urinary Protein 3 (MUP) | 97857; 101081 | 0.2 mL; 1.0 mL |
| HYB 211-01 Anti NGAL (human) | 100938; 100939 | 0.2 mL; 1.0 mL |
| HYB 211-01B Anti NGAL (human), biotinylated | 101921 | 0.1 mL |
| HYB 211-02 Anti NGAL (human) | 100940; 100941 | 0.2 mL; 1.0 mL |
| HYB 211-02B Anti NGAL (human), biotinylated | 101922 | 0.1 mL |
| HYB 339-01 Anti Rat Alpha2u-globulin | 59133; 101079 | 0.2 mL; 1.0 mL |
| SSI-HYB 339-03 Anti Rat Alpha2u-globulin | 97859; 101080 | 0.2 mL; 1.0 mL |
| SSI-HYB 339-03B Anti Rat Alpha2u-globulin, biotinylated | 97861 | 0.1 mL |
| HYB 281-05 Anti Serum Amyloid P Component (SAP) | 56585; 101076 | 0.2 mL; 1.0 mL |
| HYB 338-01 Anti Tau Protein | 58114; 101078 | 0.2 mL; 1.0 mL |
| HYB 130-11 Anti Tetranectin (human) | 100878; 100881 | 0.2 mL; 1.0 mL |
| HYB 021-03 Anti Trypsin (human) | 100567; 100568 | 0.2 mL; 1.0 mL |
| HYB 021-03B Anti Trypsin (human), biotinylated | 101912 | 0.1 mL |
| HYB 021-08 Anti Trypsin (human) | 100569; 100570 | 0.2 mL; 1.0 mL |
| HYB 021-08B Anti Trypsin (human), biotinylated | HYB 021-08B | 0.1 mL |
| HYB 352-01 Anti Filamentous hemagglutinin (FHA) | 69602; 101055 | 0.2 mL; 1.0 mL |
| HYB 352-02 Anti Filamentous hemagglutinin_(FHA) | 69603; 101057 | 0.2 ml; 1.0 ml |
| HYB 333-01 Anti Pertussis Toxin | 59282; 100628 | 0.2 mL; 1.0 mL. |
| HYB 333-02 Anti Pertussis Toxin | 59283; 100629 | 0.2 mL; 1.0 mL |
| HYB 333-03 Anti Pertussis Toxin | 63947; 100632 | 0.2 mL; 1.0 mL |
| HYB 333-05 Anti Pertussis Toxin | 63948; 100634 | 0.2 mL; 1.0 mL |
| HYB 333-06 Anti Pertussis Toxin | 63949; 100698 | 0.2 mL; 1.0 mL |
| HYB 333-09 Anti Pertussis Toxin | 63950; 101054 | 0.2 mL; 1.0 mL |
| HYB 333-02 Anti Pertussis Toxin, biotinylated | 59284 | 0.1mL |
| HYB 133-01 Anti Factor lX (human, Christmas factor | 100892; 100893 | 0.2 mL; 1.0 mL |
| HYB 133-09 Anti Factor lX(human, Christmas factor) | 100894; 100895 | 0.2 mL; 1.0 mL |
| HYB 051-04 Anti Fibrinogen (human) | 100820; 100821 | 0.2 mL; 1.0 mL |
| HYB 051-05 Anti Fibronectin (human) | 100824; 100825 | 0.2 mL; 1.0 mL |
| HYB 010-03 Anti Hirudin | 100560; 100561 | 0.2 mL; 1.0 mL |
| HYB 237-01 Anti Protein c (human) | 100947; 100948 | 0.2 mL; 1.0 mL |
| HYB 237-05 Anti Protein C (human) | 100949; 100950 | 0.2 mL; 1.0 mL |
| HYB 232-11 Anti Protein S (human) | 100945; 100946 | 0.2 mL; 1.0 mL |
| HYB 109-04 Anti Thrombin (human) | 100859; 100860 | 0.2 mL; 1.0 mL |
| HYB 060-01 Anti von Willebrand factor (human, vWf) | 100828; 100829 | 0.2 mL; 1.0 mL |
风险提示:丁香通仅作为第三方平台,为商家信息发布提供平台空间。用户咨询产品时请注意保护个人信息及财产安全,合理判断,谨慎选购商品,商家和用户对交易行为负责。对于医疗器械类产品,请先查证核实企业经营资质和医疗器械产品注册证情况。
 文献和实验
文献和实验to 50. If monoclonal antibodies are desired, once you have a "good" polyclonal and a reliable screening method proceed to the next step. Rabbits: Rabbits are immunized essentially as described above. Injections: First in Freund''s
. The choice between using polyclonal and/or monoclonal antibodies will govern the basic approach. Each approach will present its own advantages/disadvantages including cost, ability to produce a high yield, quality, and a need for standardization. The context
Several antireceptor monoclonal antibodies (MAbs) have been described to compete with ligands for receptor binding. The possibility that structures derived from the hypervariable or complementarity determining regions (CDR) of such antibodies
 技术资料
技术资料暂无技术资料 索取技术资料










